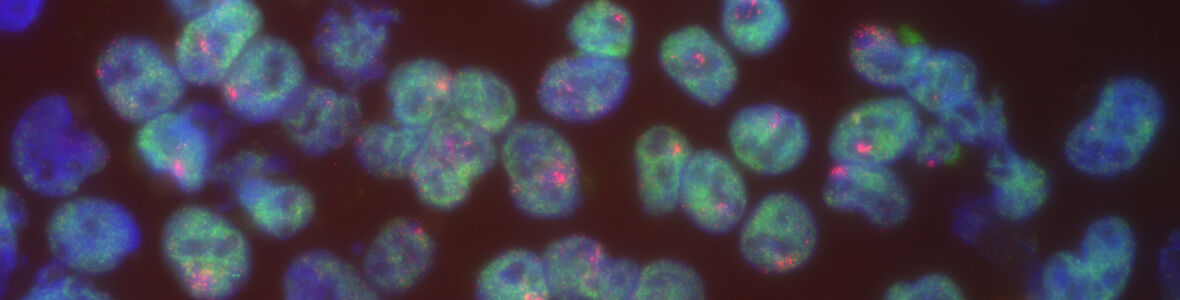

Dissertation Phase
After the passing the Preliminary Exam, students are official PhD candidates and move on to the Dissertation Research phase of their studies.
Mentor | Committee | Chair | Lab Notebooks | Students in year 6+ | Permission to Write & Defend | Presentation & Defense | Graduation
The Thesis Mentor
CAMB students must carry out their thesis research under the mentorship of a faculty member of the Cell and Molecular Biology Graduate Group. The Thesis Mentor is the most important individual the student will interact with in the course of their graduate training. For this reason students should carefully evaluate their three rotation experiences in choosing the Mentor. If necessary the student can do additional rotations. At the end of all the rotations the Mentor is chosen and thesis research should commence as soon as possible. The Thesis Mentor is responsible for supporting PhD students beginning June 1st of the PhD student's second year or the MD/PhD student’s fourth year. Please see the FY24 Mentor Cap Memo from BGS for more detailed financial information.
Responsibilities of the Thesis Mentor
The thesis mentor’s primary responsibility is to guide and inspire students to reach their scholarly potential. A mentor is expected to promote a student’s intellectual growth, guide research progress, and uphold high academic and research standards.
An effective mentor:
- Is supportive, accessible, encouraging, respectful, and fosters open communication
- Ensures that the research environment is safe, equitable, and free from harassment and discrimination
- Models ethical behavior, and discusses ethical implications of the research
- Communicates expectations regarding work habits and behavior in the laboratory
- Works closely with the student to design a meaningful thesis project
- Provides consistent and constructive feedback about laboratory skills, writing, and presentations, being honest when performance does not meet expectations
- Encourages student presentations at local, national and international conferences
- Acknowledges student contributions
- Facilitates timely publication of student research
- Pursues opportunities to secure resources necessary to provide stable financial support
- Prepares the student for chosen career path by discussing goals and plans for achieving them
- Helps the student obtain a postdoctoral fellowship or other position after graduation, and provides an honest letter of recommendation
A more complete description of mentor responsibilities can be found at the two sources below:
“Advising & Mentoring PhD Students" via the University of Pennsylvania
“Compact Between Biomedical Graduate Students and Their Research Advisors” via AAMC
CAMB membership requires fulfillment of these responsibilities by all faculty who serve as thesis mentors.
Mentor | Committee | Chair | Lab Notebooks | Students in year 6+ | Permission to Write & Defend | Presentation & Defense | Graduation
The Thesis Committee
Within six months of passing the preliminary exam, the student must form a Thesis Committee, and have their first committee meeting. Failure to formulate a Thesis Committee within this time frame will result in the student being placed on academic probation. The Thesis Committee must meet at least once a year for Ph.D. students and every six months for combined degree students to monitor student progress. It is the student’s responsibility to initiate the scheduling of these meetings. The Program Chair will monitor the frequency of thesis committee meetings.
The Thesis Committee will be comprised of four (or more) faculty (not including the Thesis Mentor), at least three of whom must be members of the CAMB Graduate Group. One of the four faculty is designated as committee chair, and they must be a CAMB member. The committee should be constituted to include breadth as well as expertise in the particular research area of thesis work. No more than one faculty member per lab can serve on a student's committee. The Thesis Mentor is a non-voting, ex-officio member of the thesis committee.
The Thesis Committee is the student's advocate and advises the student on scientific direction. The thesis committee, in consultation with the mentor and the student, decides whether a student may defend their thesis. It may intervene if there is a serious disagreement between the student and the mentor. If a serious disagreement arises between committee members, the committee Chair should inform the relevant Program Chair. The Program Chair must approve the composition of each thesis committee in their Program, and when necessary, at their discretion, may add additional members or reformulate a committee. If a dispute arises between a student and the thesis committee, and the student requests it, the decisions of a thesis committee will be reviewed by the CAMB Executive Committee.
The graduate student and their Program Chair shall jointly select the members of the Thesis Committee. The student should submit a list of potential committee members, indicating which faculty will serve as committee chair, to their Program Chair in writing. The Program Chair will respond in writing to approve the committee composition or make recommendations for other candidates. The Graduate Group Chair will adjudicate any disagreement on the composition of the Thesis Committee.
The Thesis Committee and the committee chair must be registered with the Graduate Group Office as soon as it is approved. Students must contact the Graduate Group Office before each thesis committee meeting is held. The student will provide the members of the thesis committee and the Graduate Group Office with a brief progress report including results obtained and experimental plans, no longer than 2-3 pages, one week prior to the meeting. The Graduate Group Office will then send thesis committee evaluation forms (appendix) to the committee chair. The committee chair will write an overall summary of the committee's decisions. The summary will be returned to the Graduate Group Office to be placed in the student's academic file, and a copy will be forwarded to the student.
Thesis Committee Responsibilities
The primary charge of a thesis committee is to evaluate the scientific progress of the student and to suggest directions in research that will culminate in a successful thesis. The committee as a whole, and as individual members, should be willing as well to help in other facets of the student’s scientific and professional development.
Effective mentorship from members of a thesis committee involves:
- Critical evaluation of the student’s scientific progress, and of the competencies that relate to scientific pursuit in general.
- Feedback to the thesis mentor and/or student regarding feasibility of research goals and plans, especially when the proposed plan is incompatible with timely completion of the thesis.
- Cross-checks on training in responsible conduct of research and experimental design as it relates to reproducibility, verifying that the lab notebook is complete and well-managed.
- An active interest in the student’s professional development, using the student’s IDP as one point of discussion.
- Interactions that promote open dialog on science, skills, interests, and aspirations.
- A willingness to step in should problems in the dynamics between the student and thesis mentor and/or other elements of the research environment be recognized.
Faculty should refer to the Thesis Committee Responsibilities and Expectations document for more information.
Mentor | Committee | Chair | Lab Notebooks | Students in year 6+ | Permission to Write & Defend | Presentation & Defense | Graduation
Responsibilities of the Thesis Committee Chair
The chair of the thesis committee plays the primary role in ensuring that the committee meets all of its responsibilities.
- Review student progress report, plans and IDP prior to the thesis committee meeting (provided by student one week prior to meeting).
- Prepare Thesis Committee Meeting Evaluation report (also found under Forms) and distribute to committee, student, advisor and CAMB office within one week of meeting. Please make substantive recommendations and define expectations. The full committee must approve the report.
- Communicate any concerns about student progress/plans or student-advisor interaction to program chair immediately following the thesis committee meeting.
- Serve as a key advocate for student success, being available to discuss any issues of importance, including thesis project, career planning, etc.
Mentor | Committee | Chair | Lab Notebooks | Students in year 6+ | Permission to Write & Defend | Presentation & Defense | Graduation
Guidelines for Maintaining a Laboratory Notebook
BGS has mandated that all graduate groups ensure that students properly maintain laboratory notebooks and records. Students are requested to bring their most recent laboratory notebook to each thesis committee meeting. The thesis committee chair will appoint a committee member to review the notebook. The purpose of this review is to ensure that students record their primary data in a manner that allows for appropriate analysis, reanalysis and documentation as necessary. The objective is NOT to monitor the precise content of the notebooks, but to ensure that these essential records of research activity are maintained in an acceptable format.
A one-size-fits-all notebook is neither feasible nor appropriate, given the diversity in types of research. BGS has identified four major classes of notebooks, laid out in Acquisition and Management of Data - Policies and Guidelines, which include guidelines for each type of notebook. However, all laboratory notebooks, regardless of type, should be:
- As permanent and, subsequent to each entry, as immutable as possible
Entries can be annotated but never altered. - Complete
It is imperative with primary data to document everything, to document everything as soon as possible, and to document everything whether it’s ‘good’ or ‘bad,’ ‘right’ or ‘wrong,’ even if an experiment is terminated prematurely. Omitting data is dishonest. - Well-organized and easily interpreted by others
The notebook should be easily read and understood by any number of other individuals, including principal investigators, other lab members, members of the thesis committee, and Penn- or non-Penn-affiliated auditors tasked with monitoring and authentication, including the ability to:- locate any piece/set of primary data and identify the experimental conditions under which it was collected;
- identify and locate all primary data associated with a given experiment, project, analysis, or publication; and
- determine how data are used to form decisions regarding next steps.
- Always accessible to the principle investigator
The principle investigator must be able to examine a notebook at any point in time. The principle investigator is tasked with the responsibility of authenticating, on a frequent basis, that they have evaluated incremental entries and that the notebook is compatible with the dictates of the agreed-upon system relating to management of the data. - Secure
Notebooks and other records should be kept secure from unauthorized access, theft, and destruction through:- storage that safeguards access, and
- periodic, securely stored backups.
Notebooks/records should be checked at each thesis committee meeting. If weaknesses are found in notebook/record organization, then the student and PI will receive guidance from the thesis committee on necessary improvements. It is the responsibility of the PI and the student to fully address issues identified by the thesis committee.
Mentor | Committee | Chair | Lab Notebooks | Students in year 6+ | Permission to Write & Defend | Presentation & Defense | Graduation
Students in year 6+
Students who have not received permission to write the thesis by the start of Year 6 are required to meet with the Thesis Committee every 6 months. The purpose of these meetings is to ensure that a detailed and realistic plan is in place for completion of experiments, publication of the work, and conclusion of thesis work. Frequent progress reports allow the committee to provide timely guidance in modifying the plan as necessary. The student is responsible for scheduling these meetings, and failure to do so may result in dismissal from the program with a Terminal Master’s degree. Students are advised to copy their Program Coordinator when contacting committee members to schedule a meeting. Note that these later Thesis Committee Meetings should be viewed primarily as a forum for progress reports/updates/future plans and should not include a prolonged presentation of all data presented at previous Thesis Committee Meetings.
Students starting Year 8 without permission to write are required to meet with the Thesis Committee, Program Chair, and one additional member of the Executive Committee. At this meeting, the student will present to the aforementioned group their completed work, plans for future experiments, and a detailed timeline for completion of their thesis. The faculty in attendance will determine whether the student will be allowed to continue towards completion of the degree, or will be dismissed from the Graduate Group, with a Terminal Masters degree. The student may appeal the decision to dismiss to the Graduate Group chair.
Mentor | Committee | Chair | Lab Notebooks | Students in year 6+ | Permission to Write & Defend | Presentation & Defense | Graduation
Permission to Write and Defend the Thesis
The Graduate Group requires a dissertation that represents a definitive contribution to scientific knowledge and that demonstrates the student’s ability to perform independent research. The dissertation should contain experimental information that answers a stated question and should display a logical progression of scientific thought. At least one lead-author peer-reviewed research publication should be in press prior to the granting of permission to write and defend the thesis. The thesis committee has the final authority to grant permission to write and defend the thesis. However, in cases where this standard is not met, the thesis committee must consult with the Program Chair prior to granting permission to write the thesis.
When permission to write is granted, the Permission to Write form must be signed by the committee chair and thesis advisor and returned to the Graduate Group Office. The committee should also agree on a timeline that includes an approximate date for the defense. This is necessary to ensure that a defense schedule convenient for all committee members can be arranged and that an appropriate room can be reserved. A draft of the thesis must be presented to each committee member and the CAMB office no later than two weeks prior to the scheduled defense. Failure to do this may result in cancellation of the scheduled thesis defense. Prior to distributing the dissertation to the thesis committee, it must be approved by the thesis advisor. It is typical for members of the thesis committee to ask for revisions prior to the dissertation’s final submission; such revisions can also be requested at the thesis defense.
The dissertation is the document that summarizes the student’s experimental work, formally stating the hypothesis (or hypotheses), the background for forming the hypothesis, and the complete, logical set of experiments and methods used to prove or disprove the hypothesis. It describes primarily data obtained independently by the student, including those generated from incomplete and/or rotation projects (if desired), but may also describe collaborative work. For the latter, it is critical that the student be the primary author and provides the appropriate acknowledgments to other contributors. In addition to being a document that summarizes the research accomplishments of the student, the dissertation is also an invaluable lab resource and should be written as such.
The basic outline of the dissertation comprises five sections:
- General Introduction, which is intended to review in depth the literature that places all of the work in context and to state the initial hypothesis or hypotheses;
- Materials and Methods, which should be complete and sufficiently detailed so that others can repeat the experiments without undue literature searches;
- Results, which typically consists of more than one chapter, with each chapter corresponding to a completed or submitted manuscript or to work in progress. The chapters can contain their own Introductions (these cannot replace the General Introduction described above), Materials and Methods and Discussion sections. The text of these chapters may be more detailed than a completed or submitted manuscript; for example, the Methods should be completely described so that others can repeat the experiments or use the same technology.
- Conclusions/Future Directions, which defines the major conclusions and advances accomplished, and places these within the context of related areas of research and major unanswered questions in the field. This chapter should not just summarize the results obtained, but should be a broader synthesis of the importance and implications of the work accomplished, and the major directions for future work. This section is required even if chapters in the Results section have their own Discussions.
- References. Depending on the overall organization of the dissertation, these can be included at the end of each chapter or at the end of the document.
Following this general outline, the dissertation’s overall organization is up to the student in consultation with the thesis advisor and chair of the thesis committee. The written document must conform to the dissertation rules of the University (see the Dissertation Manual issued by the Office of Graduate Studies).
Mentor | Committee | Chair | Lab Notebooks | Students in year 6+ | Permission to Write & Defend | Presentation & Defense | Graduation
The Thesis Presentation and Defense
The thesis presentation will take the form of a public lecture. The lecture should be scheduled well in advance so that a time convenient for the entire committee can be found and notices can be sent to the faculty and student membership. The Graduate Group Office needs to know the defense date, title of the thesis and place and time of the defense at least three weeks in advance. The Graduate Group Office will then send a public notice to the University community advertising the thesis defense. The Graduate Group Office is responsible for obtaining faculty sign-off of forms that are required after the thesis defense.
Every effort should be made to have the full four-member thesis committee present at the thesis defense. If a thesis committee member cannot be present at the defense, they may provide to the committee chair approval of and/or comments concerning the thesis prior to the defense. If that is not possible, the student is responsible for finding a substitute committee member, with the approval of their program chair. Following general questioning during the public phase of the presentation the thesis defense will commence. The defense is open only to the thesis committee and mentor. The decision on approval of the thesis will be made solely by a majority vote of the committee. The student should anticipate that the committee may require changes to the thesis that could include additional writing, editing and re-evaluation of data. Such changes must then be approved by the committee before the thesis is deposited. For this reason, it is imperative that thesis defenses be scheduled no later than two weeks before the deadline for depositing theses.
Please refer to the Graduation Checklist, which details all of these processes and procedures.
Mentor | Committee | Chair | Lab Notebooks | Students in year 6+ | Permission to Write & Defend | Presentation & Defense | Graduation
Graduation Procedures
The Office of the Provost sets three graduation dates each year in May, August, and December. A formal commencement ceremony is held in May. The Graduate Group Office will distribute a calendar for each degree period, giving the deadlines for signing up for graduation, and for defending and depositing the thesis. If a student is not able to graduate after they have signed up, they must re-apply for the next degree period. The Graduate Group Office will guide students through the thesis submission and graduation scheduling.
Please refer to the Graduation Calendar, which details the deadlines for each graduation cycle.